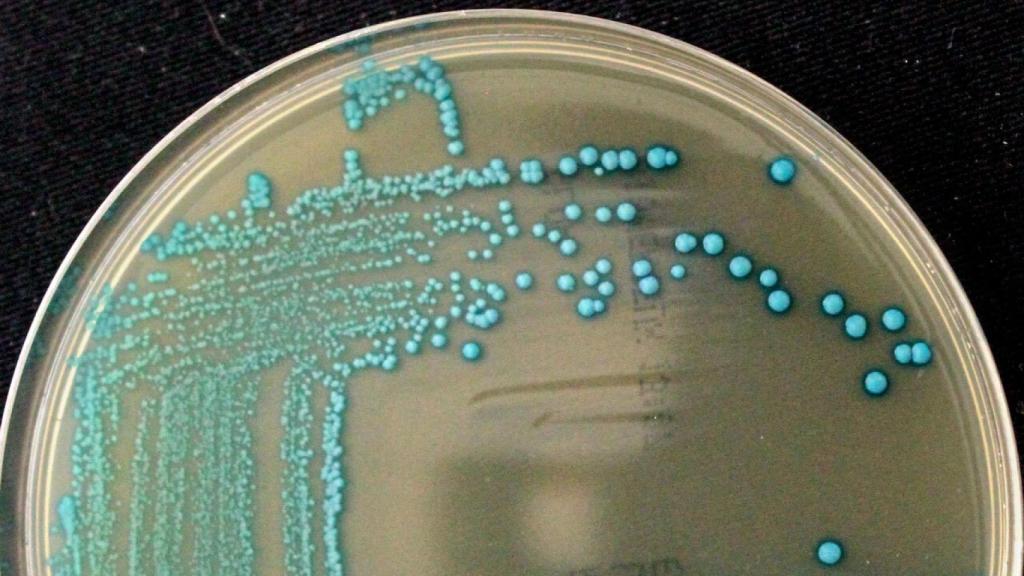
Listeria cossartiae / Catharine Carlin, Cornell University.

Listeria cossartiae / Catharine Carlin, Cornell University.
Alerta sanitaria: descubren un nuevo tipo de listeria que escapa a los controles
La nueva especie del género Listeria no se mueve como las demás, lo que hace más difícil detectar la contaminación alimentaria.
Noticias relacionadas
Aunque existen diversos tipos de bacterias responsables de intoxicaciones alimentarias, siendo la más común y conocida la Escherichia coli o simplemente E. coli, aún hoy en día se están estudiando y descubriendo cada vez más patógenos con este perjudicial potencial.
De hecho, el equipo de científicos de los alimentos de la Universidad de Cornell ha descubierto no solo una nueva bacteria, sino hasta cinco nuevas especies diferentes del género Listeria, otro de los microorganismos asociados a las infecciones alimentarias. Pero una de estas nuevas especies destaca por su capacidad para escapar a los exhaustivos controles alimentarios, según el nuevo trabajo publicado en the International Journal of Systemic and Evolutionary Microbiology.
Inicialmente, los investigadores quisieron analizar la prevalencia de Listeria en el suelo agrícola de los Estados Unidos. La sorpresa llegó al identificar estas nuevas especies de Listeria, lo cual a su vez ayudará a mejorar los controles de las instalaciones alimentarias según los investigadores: hasta ahora podrían haberse pasado por alto en estos controles, al ser especies totalmente desconocidas.
Como bien comenta Catharine R. Carlin, autora principal del estudio, la investigación ampliará la base de conocimientos y la comprensión de la diversidad de Listeria, evitando así confusión y errores a nivel de comercialización alimentaria, y también evitando potenciales casos de intoxicación.
La nueva especie más destacada fue L. immobilis, la cual no puede moverse, como su propio nombre indica. La Listeria en general tiene gran capacidad de movimiento, como es el caso de L. monocytogenes, una conocida bacteria capaz de productir intoxicaciones alimentarias, y que suele usarse como prueba de detección de toxinfecciones. En este caso, L. immobilis sería la especie más peligrosa: al quedarse quieta, es más difícil detectarla.
De hecho, dado que varias especies de listeria suelen coexistir en el mismo ambiente, se sabe que el crecimiento de L. monocytogenes en los alimentos sirve como punto de verificación en las prácticas de saneamiento. Así, si se detecta esta bacteria, es probable que haya otras, y de diferentes especies.
L. monocytogenes en especial suele tener una gran potencial infectivo en las plantas de procesados de alimentos, por lo que dichas plantas deben mantenerse limpias. Se considera que la listeriosis tiene una mortalidad del 20-30%, incluso si se trata con antibióticos, como indica la FDA de los Estados Unidos. Por su parte, los CDC estadounidenses estiman que existen alrededor de 1.600 casos de listeriosis cada año en el país, y casi 260 muertes por dicho motivo.
Las demás nuevas listerias
Por su parte, como puntualiza el coautor del estudio Martin Wiedmann, profesor de Seguridad Alimentaria y Ciencia de los alimentos, es muy probable que los actuales protocolos de saneamiento alimentario deban reevaluarse: es necesario comprender las similitudes entre las especies de listeria, pero también sus diferencias, como es el caso de la mencionada L. immobilis.
Durante el estudio se tomaron muestras de suelo de todo Estados Unidos, y muestras de agua agrícola del estado de Nueva York. En total, se aislaron 27 microorganismos del género Listeria, pero que no podían clasificarse a nivel de especie como tal. Tras realizarse las pruebas de laboratorio basadas en secuencia del genoma, se identificaron las cinco especies nuevas.
Tras nombrar a L. immobilis por su característica única, se identificaron otras 4:
- L. cossartiae, en honor a Pascale Cossart, bacterióloga del Instituto Pasteur de París.
- L. farberi, en honor a Jeff Farber, microbiólogo de la Universidad de Guelph, en Canadá.
- L. portnoyii, en honor a Daniel Portnoy, microbiólogo de la Universidad de California, en Berkeley.
- L. rustica, en honor a su origen rural y la palabra latina "rusticus".
Desde el pasado año 2010, el grupo de investigación de Wiedmann ha descubierto 13 de las actuales 26 especies clasificadas en el género Listeria, y su objetivo es poder "diferenciar los buenos de los malos". Y es que hay que terminar recordando que no todos los microorganismos son patógenos, y tampoco todas las especies de listeria lo son.



